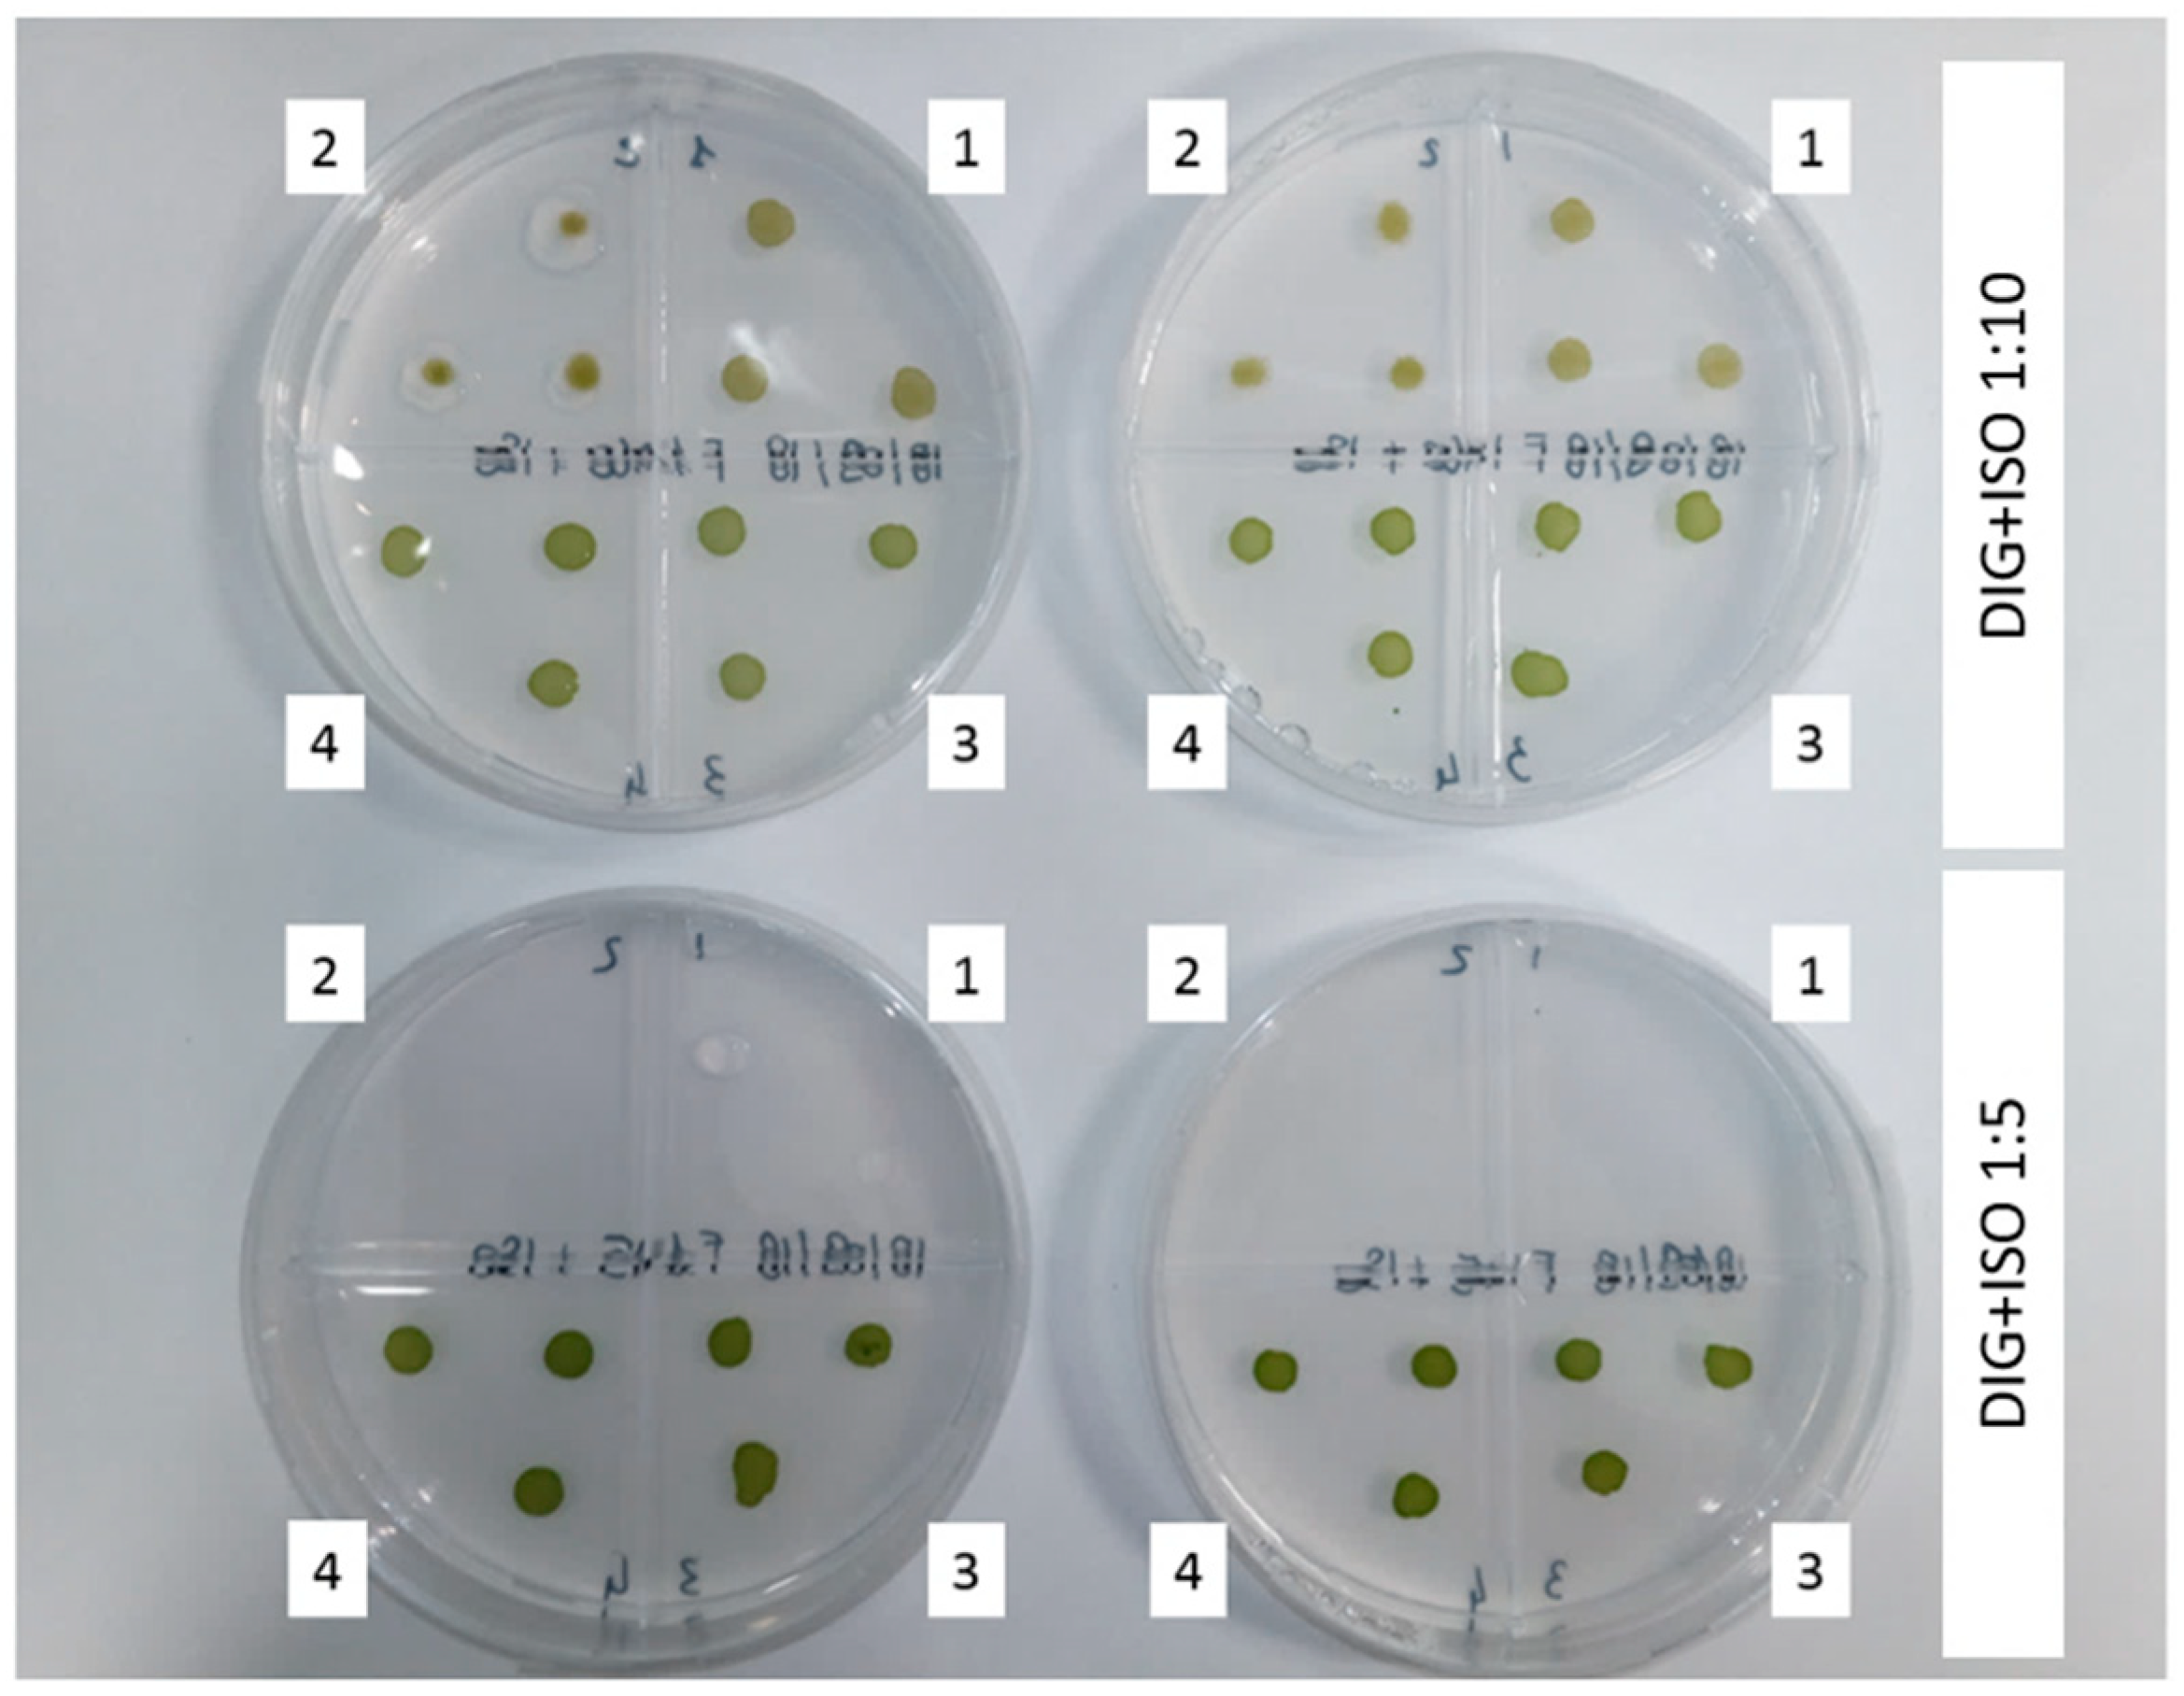
Energies 13 04880 g001 Energies 13 04880 g001

Anaerobic Co-Digestion Effluent as Substrate for Chlorella vulgaris and Scenedesmus obliquus Cultivation
Abstract
1. Introduction
2. Material and Methods
2.1. Anaerobic Co-Digestion Effluent Characterization
2.2. Microalgae Strains, Maintenance and Analysis
2.3. Petri Plate and Nile Red Qualitative Test
2.4. Microalgae Growth: Batch Experiment Set-Up
2.5. Analytical Method
3. Discussion
3.1. Petri Plate: Nile Red Coloring Test
3.2. Batch Test: OFMSW-WAS Diluted 1:5 with ISO 8692 and Tap Water
3.3. Nutrient Removal and Chlorophyll a, b and Carotenoid Accumulation
4. Conclusions
Author Contributions
Funding
Acknowledgments
Conflicts of Interest
References
- Nkoa, R. Agricultural benefits and environmental risks of soil fertilization with anaerobic digestates: A review. Agron. Sustain. Dev. 2013, 34, 473–492. [Google Scholar] [CrossRef]
- Levine, R.B.; Costanza-Robinson, M.S.; Spatafora, G.A. Neochloris oleoabundans grown on anaerobically digested dairy manure for concomitant nutrient removal and biodiesel feedstock production. Biomass Bioenergy 2010, 35, 40–49. [Google Scholar] [CrossRef]
- Lukehurst, C.T.; Frost, P.; Al Seadi, T. Utilisation of digestate from biogas plants as biofertiliser. IEA Bioenergy 2010, 2010, 1–36. [Google Scholar]
- Koutra, E.; Economou, C.N.; Tsafrakidou, P.; Kornaros, A.M. Bio-Based Products from Microalgae Cultivated in Digestates. Trends Biotechnol. 2018, 36, 819–833. [Google Scholar] [CrossRef]
- Tyagi, V.K.; Fdez-Güelfo, L.; Zhou, Y.; Álvarez-Gallego, C.; Romero-García, L.I.; Ng, W.J. Anaerobic co-digestion of organic fraction of municipal solid waste (OFMSW): Progress and challenges. Renew. Sustain. Energy Rev. 2018, 93, 380–399. [Google Scholar] [CrossRef]
- Chuka-Ogwude, D.; Ogbonna, J.; Moheimani, N.R. A review on microalgal culture to treat anaerobic digestate food waste effluent. Algal Res. 2020, 47, 101841. [Google Scholar] [CrossRef]
- Lardon, L.; Hélias, A.; Sialve, B.; Steyer, J.-P.; Bernard, O. Life-Cycle Assessment of Biodiesel Production from Microalgae. Environ. Sci. Technol. 2009, 43, 6475–6481. [Google Scholar] [CrossRef]
- Zhu, L. Microalgal culture strategies for biofuel production: A review. Biofuels Bioprod. Biorefining 2015, 9, 801–814. [Google Scholar] [CrossRef]
- Zuliani, L.; Frison, N.; Jelic, A.; Fatone, F.; Bolzonella, D.; Ballottari, M. Microalgae Cultivation on Anaerobic Digestate of Municipal Wastewater, Sewage Sludge and Agro-Waste. Int. J. Mol. Sci. 2016, 17, 1692. [Google Scholar] [CrossRef]
- Erkelens, M.; Ward, A.; Ball, A.S.; Lewis, D. Microalgae digestate effluent as a growth medium for Tetraselmis sp. in the production of biofuels. Bioresour. Technol. 2014, 167, 81–86. [Google Scholar] [CrossRef]
- Chew, K.W.; Yap, J.Y.; Show, P.L.; Suan, N.H.; Juan, J.C.; Ling, T.C.; Lee, D.-J.; Chang, J.-S. Microalgae biorefinery: High value products perspectives. Bioresour. Technol. 2017, 229, 53–62. [Google Scholar] [CrossRef] [PubMed]
- Heaven, S.; Milledge, J.J.; Zhang, Y. Comments on “Anaerobic digestion of microalgae as a necessary step to make microalgal biodiesel sustainable”. Biotechnol. Adv. 2011, 29, 164–167. [Google Scholar] [CrossRef] [PubMed]
- Sayedin, F.; Kermanshahi-Pour, A.; He, Q.S.; Tibbetts, S.M.; LaLonde, C.G.; Brar, S.K. Microalgae cultivation in thin stillage anaerobic digestate for nutrient recovery and bioproduct production. Algal Res. 2020, 47, 101867. [Google Scholar] [CrossRef]
- Xu, J.; Zhao, Y.; Zhao, G.; Zhang, H. Nutrient removal and biogas upgrading by integrating freshwater algae cultivation with piggery anaerobic digestate liquid treatment. Appl. Microbiol. Biotechnol. 2015, 99, 6493–6501. [Google Scholar] [CrossRef] [PubMed]
- Dickinson, K.; Bjornsson, W.J.; Garrison, L.; Whitney, C.; Park, K.; Banskota, A.; McGinn, P.J. Simultaneous remediation of nutrients from liquid anaerobic digestate and municipal wastewater by the microalga Scenedesmus sp. AMDD grown in continuous chemostats. J. Appl. Microbiol. 2014, 118, 75–83. [Google Scholar] [CrossRef]
- Cai, T.; Park, S.Y.; Racharaks, R.; Li, Y. Cultivation of Nannochloropsis salina using anaerobic digestion effluent as a nutrient source for biofuel production. Appl. Energy 2013, 108, 486–492. [Google Scholar] [CrossRef]
- Serejo, M.L.; Posadas, E.; Boncz, M.A.; Blanco, S.; García, P.; Muñoz, R. Influence of Biogas Flow Rate on Biomass Composition During the Optimization of Biogas Upgrading in Microalgal-Bacterial Processes. Environ. Sci. Technol. 2015, 49, 3228–3236. [Google Scholar] [CrossRef]
- Tan, X.; Chu, H.; Zhang, Y.; Yang, L.; Zhao, F.; Zhou, X. Chlorella pyrenoidosa cultivation using anaerobic digested starch processing wastewater in an airlift circulation photobioreactor. Bioresour. Technol. 2014, 170, 538–548. [Google Scholar] [CrossRef]
- Xia, A.; Murphy, J.D. Microalgal Cultivation in Treating Liquid Digestate from Biogas Systems. Trends Biotechnol. 2015, 34, 264–275. [Google Scholar] [CrossRef]
- Uggetti, E.; Sialve, B.; Latrille, E.; Steyer, J.-P. Anaerobic digestate as substrate for microalgae culture: The role of ammonium concentration on the microalgae productivity. Bioresour. Technol. 2014, 152, 437–443. [Google Scholar] [CrossRef]
- Cai, T.; Ge, X.; Park, S.Y.; Li, Y. Comparison of Synechocystis sp. PCC6803 and Nannochloropsis salina for lipid production using artificial seawater and nutrients from anaerobic digestion effluent. Bioresour. Technol. 2013, 144, 255–260. [Google Scholar] [CrossRef] [PubMed]
- Cho, S.; Luong, T.T.; Lee, D.; Oh, Y.-K.; Lee, T. Reuse of effluent water from a municipal wastewater treatment plant in microalgae cultivation for biofuel production. Bioresour. Technol. 2011, 102, 8639–8645. [Google Scholar] [CrossRef] [PubMed]
- Cho, S.; Lee, N.; Park, S.; Yu, J.; Luong, T.T.; Oh, Y.-K.; Lee, T. Microalgae cultivation for bioenergy production using wastewaters from a municipal WWTP as nutritional sources. Bioresour. Technol. 2013, 131, 515–520. [Google Scholar] [CrossRef] [PubMed]
- Ioannou-Ttofa, L.; Puma, G.L.; Fatta-Kassinos, D. Treatment of winery wastewater by physicochemical, biological and advanced processes: A review. J. Hazard. Mater. 2015, 286, 343–368. [Google Scholar] [CrossRef]
- Riaño, B.; Molinuevo, B.; García-González, M.C. Treatment of fish processing wastewater with microalgae-containing microbiota. Bioresour. Technol. 2011, 102, 10829–10833. [Google Scholar] [CrossRef]
- Larsdotter, K.; Microbiology, E. Wastewater treatment with microalgae—A literature review. Vatten 2006, 62, 31–38. [Google Scholar] [CrossRef]
- Abe, K.; Imamaki, A.; Hirano, M. Removal of nitrate, nitrite, ammonium and phosphate ions from water by the aerial microalga Trentepohlia aurea. J. Appl. Phycol. 2002, 14, 129–134. [Google Scholar] [CrossRef]
- Li, X.; Yang, W.L.; He, H.; Wu, S.; Zhou, Q.; Yang, C.; Zeng, G.; Luo, L.; Lou, W. Responses of microalgae Coelastrella sp. to stress of cupric ions in treatment of anaerobically digested swine wastewater. Bioresour. Technol. 2018, 251, 274–279. [Google Scholar] [CrossRef]
- Prajapati, S.K.; Malik, A.; Vijay, V.K. Comparative evaluation of biomass production and bioenergy generation potential of Chlorella spp. through anaerobic digestion. Appl. Energy 2014, 114, 790–797. [Google Scholar] [CrossRef]
- Prajapati, S.K.; Kumar, P.; Malik, A.; Vijay, V.K. Bioconversion of algae to methane and subsequent utilization of digestate for algae cultivation: A closed loop bioenergy generation process. Bioresour. Technol. 2014, 158, 174–180. [Google Scholar] [CrossRef]
- Moretto, G.; Ardolino, F.; Piasentin, A.; Girotto, L.; Cecchi, F. Integrated anaerobic codigestion system for the organic fraaction of municipal solid waste and sewage sludge treatment: An Italian case study. J. Chem. Technol. Biotechnol. 2020, 95, 418–426. [Google Scholar] [CrossRef]
- International Standard ISO. Fresh Water Algal Growth Inhibition Test with Unicellular Green Algae, 3rd ed.; ISO: Geneva, Switzerland, 2012. [Google Scholar]
- Wang, L.; Min, M.; Li, Y.; Chen, P.; Chen, Y.; Liu, Y.; Wang, Y.; Ruan, R. Cultivation of Green Algae Chlorella sp. in Different Wastewaters from Municipal Wastewater Treatment Plant. Appl. Biochem. Biotechnol. 2009, 162, 1174–1186. [Google Scholar] [CrossRef] [PubMed]
- Greenspan, P.; Mayer, E.P.; Fowler, S.D. Nile Red: A Selective Fluorescent Stain for Intracellular Lipid Droplets. J. Cell Biol. 1985, 100, 965–973. [Google Scholar] [CrossRef] [PubMed]
- Zuriani, R.; Vigneswari, S.; Azizan, M.N.M.; Majid, M.I.A.; Amirul, A. A high throughput Nile red fluorescence method for rapid quantification of intracellular bacterial polyhydroxyalkanoates. Biotechnol. Bioprocess Eng. 2013, 18, 472–478. [Google Scholar] [CrossRef]
- Doan, T.T.Y.; Obbard, J.P. Improved Nile Red staining of Nannochloropsis sp. J. Appl. Phycol. 2011, 23, 895–901. [Google Scholar] [CrossRef]
- Alemán-Nava, G.S.; Cuellar-Bermudez, S.P.; Cuaresma, M.; Bosma, R.; Muylaert, K.; Ritmann, B.E.; Parra-Saldivar, R. How to use Nile Red, a selective fluorescent stain for microalgal neutral lipids. J. Microbiol. Methods 2016, 128, 74–79. [Google Scholar] [CrossRef]
- Chen, W.; Zhang, C.; Song, L.; Sommerfeld, M.R.; Hu, Q. A high throughput Nile red method for quantitative measurement of neutral lipids in microalgae. J. Microbiol. Methods 2009, 77, 41–47. [Google Scholar] [CrossRef]
- Jalal, K.; Shamsuddin, A.; Rahman, M.; Nurzatul, N.; Rozihan, M. Growth and Total Carotenoid, Chlorophyll a and Chlorophyll b of Tropical Microalgae (Isochrysis sp.) in Laboratory Cultured Conditions. J. Boil. Sci. 2013, 13, 10–17. [Google Scholar] [CrossRef]
- APAT-IRSA/CNR. Metodologie analitiche per il controllo della qualità delle acque. Poligr e Zecca Dello Stato Roma Italy 2003, 29, 575–581. [Google Scholar]
- APHA; AWWA; WEF. Standard Methods for Examination of Water and Wastewater, 22nd ed.; Public Health Association: Washington, DC, USA, 2012; p. 1360. ISBN 978-087553-013-0. Available online: http://www.standardmethods.org/ (accessed on 17 September 2020).
- Miazek, K.; Ledakowicz, S. Chlorophyll extraction from leaves, needles and microalgae: A kinetic approach. Int. J. Agric. Biol. Eng. 2013, 6, 107–115. [Google Scholar] [CrossRef]
- Lichtenthaler, H.K.; Buschmann, C. Chlorophylls and carotenoids: Measurement and characterization by UV-VIS spectroscopy. Curr. Protoc. Food Anal. Chem. 2001, 1, F4-3. [Google Scholar] [CrossRef]
- Prajapati, S.K.; Kaushik, P.; Malik, A.; Vijay, V.K. Phycoremediation and biogas potential of native algal isolates from soil and wastewater. Bioresour. Technol. 2013, 135, 232–238. [Google Scholar] [CrossRef] [PubMed]
- He, Q.; Yang, H.; Wu, L.; Hu, C. Effect of light intensity on physiological changes, carbon allocation and neutral lipid accumulation in oleaginous microalgae. Bioresour. Technol. 2015, 191, 219–228. [Google Scholar] [CrossRef] [PubMed]
- Powell, E.O. Growth Rate and Generation Time of Bacteria, with Special Reference to Continuous Culture. J. Gen. Microbiol. 1956, 15, 492–511. [Google Scholar] [CrossRef] [PubMed]
- Pancha, I.; Chokshi, K.; George, B.; Ghosh, T.; Paliwal, C.; Maurya, R.; Mishra, S. Nitrogen stress triggered biochemical and morphological changes in the microalgae Scenedesmus sp. CCNM 1077. Bioresour. Technol. 2014, 156, 146–154. [Google Scholar] [CrossRef] [PubMed]
- Bjornsson, W.J.; Nicol, R.W.; Dickinson, K.E.; McGinn, P.J. Anaerobic digestates are useful nutrient sources for microalgae cultivation: Functional coupling of energy and biomass production. J. Appl. Phycol. 2013, 25, 1523–1528. [Google Scholar] [CrossRef]
- Massa, M.; Buono, S.; Langellotti, A.L.; Castaldo, L.; Martello, A.; Paduano, A.; Sacchi, R.; Fogliano, V. Evaluation of anaerobic digestates from different feedstocks as growth media for Tetradesmus obliquus, Botryococcus braunii, Phaeodactylum tricornutum and Arthrospira maxima. New Biotechnol. 2017, 36, 8–16. [Google Scholar] [CrossRef]
- Veronesiv, D.; D’Imporzano, G.; Salati, S.; Adani, F. Pre-treated digestate as culture media for producing algal biomass. Ecol. Eng. 2017, 105, 335–340. [Google Scholar] [CrossRef]
- Ledda, C.; Idà, A.; Allemand, D.; Mariani, P.; Adani, F. Production of wild Chlorella sp. cultivated in digested and membrane-pretreated swine manure derived from a full-scale operation plant. Algal Res. 2015, 12, 68–73. [Google Scholar] [CrossRef]
- Kim, G.-Y.; Yun, Y.-M.; Shin, H.-S.; Kim, H.-S.; Han, J.-I. Scenedesmus-based treatment of nitrogen and phosphorus from effluent of anaerobic digester and bio-oil production. Bioresour. Technol. 2015, 196, 235–240. [Google Scholar] [CrossRef] [PubMed]
- Gentili, F.G. Microalgal biomass and lipid production in mixed municipal, dairy, pulp and paper wastewater together with added flue gases. Bioresour. Technol. 2014, 169, 27–32. [Google Scholar] [CrossRef] [PubMed]
- Nuñez, V.J.; Voltolina, D.; Nieves, M.; Piña, P.; Medina, A.; Guerrero, M. Nitrogen budget in Scenedesmus obliquus cultures with artificial wastewater. Bioresour. Technol. 2001, 78, 161–164. [Google Scholar] [CrossRef]
- Park, J.; Jin, H.-F.; Lim, B.-R.; Park, K.-Y.; Lee, K. Ammonia removal from anaerobic digestion effluent of livestock waste using green alga Scenedesmus sp. Bioresour. Technol. 2010, 101, 8649–8657. [Google Scholar] [CrossRef]
- Ruiz-Martinez, A.; Garcia, N.M.; Romero, I.; Seco, A.; Ferrer, J. Microalgae cultivation in wastewater: Nutrient removal from anaerobic membrane bioreactor effluent. Bioresour. Technol. 2012, 126, 247–253. [Google Scholar] [CrossRef] [PubMed]
- Qin, L.; Wei, D.; Wang, Z.; Alam, M.A. Advantage Assessment of Mixed Culture of Chlorella vulgaris and Yarrowia lipolytica for Treatment of Liquid Digestate of Yeast Industry and Cogeneration of Biofuel Feedstock. Appl. Biochem. Biotechnol. 2019, 187, 856–869. [Google Scholar] [CrossRef] [PubMed]
- Mohammadi, M.; Mowla, D.; Esmaeilzadeh, F.; Ghasemi, Y. Cultivation of microalgae in a power plant wastewater for sulfate removal and biomass production: A batch study. J. Environ. Chem. Eng. 2018, 6, 2812–2820. [Google Scholar] [CrossRef]

| Parameter | |
|---|---|
| TS (g kg−1) | 18.3 ± 2.8 |
| VS (g kg−1) | 12.7 ± 2.2 |
| pH | 7.6 ± 0.3 |
| sCOD (mg L−1) | 300.0 ± 119.0 |
| Partial alkalinity (gCaCO3 l−1) | 1.7 ± 0.3 |
| Total alkalinity (gCaCO3 L−1) | 2.8 ± 0.5 |
| Total ammonium nitrogen (mgN-NH4+ L−1) | 573.0 ± 124.0 |
| VFA (mg L−1) | 80.0 ± 10.0 |
| ISO | TW | DIG+TW | DIG+ISO | |
|---|---|---|---|---|
| Cl− (mg L−1) | 19.0 ± 5.0 | 8.0 ± 1.0 | 57.0 ± 4.0 | 64.0 ± 1.0 |
| NO2− (mg L−1) | 0.0 ± 0.0 | 0.0 ± 0.0 | 0.0 ± 0.0 | 0.0 ± 0.0 |
| NO3− (mg L−1) | 0.5 ± 0.2 | 16.6 ± 0.1 | 12.2 ± 0.2 | 0.9 ± 1.0 |
| PO43− (mg L−1) | 0.5 ± 0.0 | 0.5 ± 0.6 | 14.5 ± 0.1 | 18.0 ± 1.0 |
| SO42− (mg L−1) | 6.1 ± 0.2 | 15.0 ± 1.0 | 13.5 ± 0.3 | 5.4 ± 0.5 |
| Na+ (mg L−1) | 18.9 ± 0.1 | 8.6 ± 0.3 | 246.0 ± 6.0 | 253.0 ± 1.0 |
| NH4+ (mg L−1) | 1.6 ± 0.1 | 0.0 ± 0.0 | 196.0 ± 13.0 | 203.0 ± 4.0 |
| K+ (mg L−1) | 1.3 ± 0.3 | 1.3 ± 0.2 | 104.0 ± 4.0 | 106.0 ± 1.0 |
| Mg2+ (mg L−1) | 3.8 ± 0.1 | 30.8 ± 0.1 | 184.0 ± 19.0 | 142.0± 5.0 |
| Ca2+ (mg L−1) | 4.0 ± 3.0 | 39.0 ± 7.0 | 490.0 ± 32.0 | 417.0 ± 9.0 |
| C. vulgaris | S. obliquus | ||
|---|---|---|---|
| OD680 | ISO | 0.40 ± 0.02 | 0.50 ± 0.10 |
| TW | 0.05 ± 0.01 | 0.50 ± 0.03 | |
| DIG+ISO | 1.08 ± 0.01 | 0.04 ± 0.03 | |
| DIG+TW | 1.20 ± 0.10 | 0.37 ± 0.05 | |
| OD750 | ISO | 0.39 ± 0.01 | 0.54 ± 0.04 |
| TW | 0.07 ± 0.01 | 0.56 ± 0.03 | |
| DIG+ISO | 0.86 ± 0.01 | 0.11 ± 0.02 | |
| DIG+TW | 1.03 ± 0.08 | 0.42 ± 0.04 | |
| Million cells mL−1 | ISO | 32.00 ± 8.00 | 29.00 ± 8.00 |
| TW | 6.00 ± 2.00 | 15.00 ± 4.00 | |
| DIG+ISO | 40.00 ± 8.00 | 2.70 ± 0.20 | |
| DIG+TW | 49.00 ± 1.00 | 4.90 ± 0.90 | |
| Dry weight (g L−1) | ISO | 0. 04 ± 0.01 | 0.08 ± 0.02 |
| TW | 0.01 ± 0.00 | 0.20 ± 0.07 | |
| DIG+ISO | 0.25 ± 0.00 | 0.16 ± 0.00 | |
| DIG+TW | 0.31 ± 0.00 | 0.23 ± 0.01 | |
| µ (d−1) | ISO | 0.20 ± 0.03 | 0.25 ± 0.30 |
| TW | 0.00 ± 0.04 | 0.17 ± 0.30 | |
| DIG+ISO | 0.23 ± 0.02 | 0.00 ± 0.00 | |
| DIG+TW | 0.25 ± 0.00 | 0.03 ± 0.20 | |
© 2020 by the authors. Licensee MDPI, Basel, Switzerland. This article is an open access article distributed under the terms and conditions of the Creative Commons Attribution (CC BY) license (http://creativecommons.org/licenses/by/4.0/).
Share and Cite
Scarponi, P.; Bonetto, A.; Bolzonella, D.; Astals, S.; Cavinato, C. Anaerobic Co-Digestion Effluent as Substrate for Chlorella vulgaris and Scenedesmus obliquus Cultivation. Energies 2020, 13, 4880. https://doi.org/10.3390/en13184880
Scarponi P, Bonetto A, Bolzonella D, Astals S, Cavinato C. Anaerobic Co-Digestion Effluent as Substrate for Chlorella vulgaris and Scenedesmus obliquus Cultivation. Energies. 2020; 13(18):4880. https://doi.org/10.3390/en13184880
Chicago/Turabian StyleScarponi, Paolina, Alessandro Bonetto, David Bolzonella, Sergi Astals, and Cristina Cavinato. 2020. "Anaerobic Co-Digestion Effluent as Substrate for Chlorella vulgaris and Scenedesmus obliquus Cultivation" Energies 13, no. 18: 4880. https://doi.org/10.3390/en13184880
APA StyleScarponi, P., Bonetto, A., Bolzonella, D., Astals, S., & Cavinato, C. (2020). Anaerobic Co-Digestion Effluent as Substrate for Chlorella vulgaris and Scenedesmus obliquus Cultivation. Energies, 13(18), 4880. https://doi.org/10.3390/en13184880

